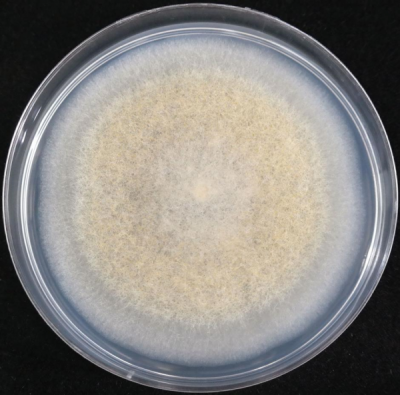

[충청뉴스큐] 환경부 소속 국립생물자원관은 이향범 전남대 교수팀과 함께 충남 청양 지역에서 털곰팡이속 신종 곰팡이인 ‘뮤코 청양엔시스’를 발견하고 최근 학계에 신종으로 인정받았다고 밝혔다.
뮤코 청양엔시스는 2019년 충남 청양에서 채집된 주홍날개꽃매미의 표면에서 분리된 것으로 털곰팡이 속으로 분류된다.
연구진은 올해 5월 국제학술지인 파이토택사에 이 곰팡이의 학술 정보를 게재하고 ‘뮤코 청양엔시스’란 이름의 신종으로 인정받았다.
털곰팡이 분류군은 토양이나 초식동물의 분변, 공기, 물 등 다양한 환경에 살고 있으나, 연구자가 많지 않아 전 세계적으로 70여 종, 우리나라에는 이번 신종 뮤코 청양엔시스를 제외하고 12종이 보고되어 있다.
이번 신종 발견은 세계적으로도 많이 알려지지 않은 새로운 곰팡이를 우리나라에서 발견했다는 측면에서 큰 의미가 있으며 털곰팡이속은 다양한 산업 소재로 쓰이고 있어 향후 활용 가능성이 기대된다.
털곰팡이속 곰팡이는 단백질, 지질, 탄수화물을 분해하는 여러 가지 효소와 다양한 대사산물을 대량 분비하는 것으로 알려졌다.
된장, 치즈 등 발효 식품산업 분야와 분해효소 생산 등 생명 산업 분야에 많이 활용되고 있다.
특히 폴리카보네이트 성분의 미세플라스틱 분해 능력을 가지고 있어, 전 세계적인 환경 난제인 플라스틱 쓰레기의 생물학적 처리에 활용될 수 있는 잠재력을 가지고 있다.
국립생물자원관은 이번 신종 발견을 발판 삼아 전문가가 많지 않은 접합균류 연구를 활성화시킬 계획이라고 전했다.
배연재 국립생물자원관장은 “곰팡이 등 지구상에 균류는 약 150만 종이 있을 것으로 추정되는데, 우리나라에는 약 4,300여 종이 보고되어 있다”며 “앞으로도 균류를 지속적으로 찾아내고 이들의 생태계 내 역할을 토대로 생물산업에 활용될 수 있는 유용가치를 연구하겠다”고 밝혔다.
저작권자 © 충청뉴스큐 무단전재 및 재배포 금지












